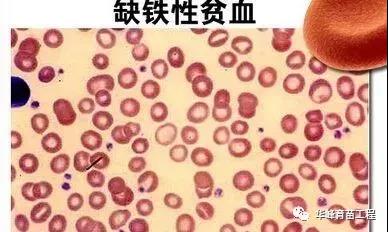
΢��ͼƬ_20201221172515.jpg

|
血是人体之本!为什么小儿与女性更容易患缺铁性贫血?由此可见缺铁性贫血是常见的营养素缺乏症,至今仍是全世界普遍的健康问题,其高危人群主要以妇女、婴幼儿、儿童为主。 缺铁性贫血的病因
1、需铁量增加、摄入量不足: (1)婴幼儿、青少年:因生长迅速,需铁量增加,如不及时补给肉类和动物肝等含铁较多的食物,很容易导致缺铁性贫血。 (2)妊娠和哺乳期:妊娠和哺乳期期间需铁量增加,加之妊娠期胃肠功能紊乱,胃酸缺乏,影响铁吸收,尤其是在多次妊娠后很容易引起缺铁性贫血。 2、铁吸收障碍: (1)胃大部切除术后:由于胃酸减少且食物快速进入空肠,绕过了十二指肠,使铁吸收减少。 (2)疾病因素:长期腹泻、慢性肠炎等疾病易导致铁吸收障碍。 3、铁丢失过多: (1)慢性胃肠道失血:与溃疡、息肉、肿瘤、感染、食管胃底静脉曲张破裂、痔疮出血等因素有关。 (2)月经过多:与节育环、子宫肌瘤、功能性子宫出血有关。 (3)呼吸道疾病咯血:与结核、支气管扩张、肺癌等因素有关。 (4)血红蛋白尿:与各种原因血管内溶血有关。 (5)血液透析:慢性肾衰竭患者易引起铁丢失。 (6)多次献血:血站对献血者每次采集血液量一般为200ml,最多不得超过400ml,两次采血间隔不少于6个月,如果献血次数过多,及易引起铁丢失。 (7)咯血。 缺铁性贫血的发病机制 1、组织缺氧:血红蛋白的主要功能是携氧并运送到全身组织,严重缺铁时血红蛋白的合成减少,血液携氧能力下降,引起全身组织器官的缺氧性损害。 2、代谢障碍:细胞中许多代谢过程需要含铁的酶和辅酶参加,缺铁时各种重要的含铁酶或含铁蛋白质如细胞色素P450氧化酶、琥珀酸脱氧酶、黄嘌呤氧化酶、肌红蛋白等活性明显降低,导致许多组织和器官发生细胞呼吸障碍,细胞代谢及功能紊乱,并易发感染。 3、红细胞异常:红细胞内含铁酶活性降低,影响脂质、蛋白质及糖代谢而引起红细胞异常,易于在脾内破坏,导致红细胞寿命缩短。 缺铁性贫血的临床表现 1、缺铁原发病表现: (1)溃疡、肿瘤、痔疮:导致黑便、血便、腹部不适症状。 (2)肠道寄生虫感染:导致腹痛、大便性状改变。 (3)月经过多。 (4)血管内溶血。 (5)肿瘤性疾病的消瘦。 2、贫血一般表现:头晕、头痛、面色苍白、乏力、易倦、心悸、活动后气短、眼花及耳鸣等。 3、组织缺铁表现: (1)神经和精神症状:容易兴奋,注意力不集中,烦躁,易怒或淡漠,易食癖,儿童生长发育迟缓、智力低下,免疫力低下、易感染,体力、耐力逐渐下降。
(2)粘膜损害:口腔炎、舌炎、舌乳头萎缩、吞咽困难。 (3)营养缺乏:毛发干枯、脱落、皮肤干燥、皱缩、指甲缺乏光泽且脆薄易裂,重者甲变平,甚至凹下成勺状(匙状甲)。 (4)胃酸缺乏和胃功能紊乱:吸收不良、食欲缺乏、便秘、慢性萎缩性胃炎等。 (5)心血管系统:心悸、气短、心脏扩大或缺血性心脏病。 贫血的体征主要表现为:皮肤黏膜苍白,毛发干燥,指甲扁平、失去光泽、易碎裂,反甲或脾脏肿大。 缺铁性贫血的诊断
1、血象:呈典型的小细胞低色素性贫血,平均血红蛋白体积<80fl,平均血红蛋白含量<26pg,平均血红蛋白浓度<32%,血红蛋白浓度降低于正常值的低限,网组织红细胞正常或轻度增加,白细胞多在正常范围,血小板正常或略升高。 2、骨髓象:增生性骨髓象,红系比例增高,幼红细胞体积减小,外形不规则。骨髓铁染色于细胞内、外铁均减少或缺乏,尤以红细胞外铁减少最为明显,是诊断缺铁性贫血的可靠指标。 3、生化指标:血清<8.95umol/L,血清总铁结合力>64.44umol/L,血清铁饱和度<15%;红细胞游离原卟啉>500ug/L,血清蛋白<20ug/L,血清运铁蛋白受体>8.5mg/L。 缺铁性贫血的主要治疗方法 1、药物治疗:治疗缺铁性贫血,就要补铁。通常都会使用铁剂的补充治疗法,每天口服补充铁元素150~200mg即可。 2、中医治疗:一般来说,缺铁性贫血是身体对于铁质吸收不好,中医治疗缺铁性贫血更具特色,而且中药治疗可以调理身体,可以从根本上养好身体,从而帮助身体吸收铁质。 3、病因治疗:缺铁性贫血从病名上看,我们可以理解为是体内铁元素缺乏引致的,所以我们最好能找出缺铁的病因,就能对症治疗,补充铁质,改善贫血的现象。 补血、益气、健脾和胃 ![]()
入标题 abcdefg 健脾补血颗粒说明书 【成份】党参,茯苓、皂矾、神曲茶、炒黑豆、白术、陈皮、甘草。 【功能主治】补血、益气、健脾和胃。用于脾虚血少所致的面黄肌瘦,食少体倦及营养性、缺铁性贫血见上述症状者。 【用法用量】口服,二岁以下0.5g/次,2-5岁1g/次,6-10岁1.5g/次,11-14岁2g/次,15岁以上3g/次,一日3次。 【批准文号】国药准字号Z20054005 健脾补血颗粒方解
|